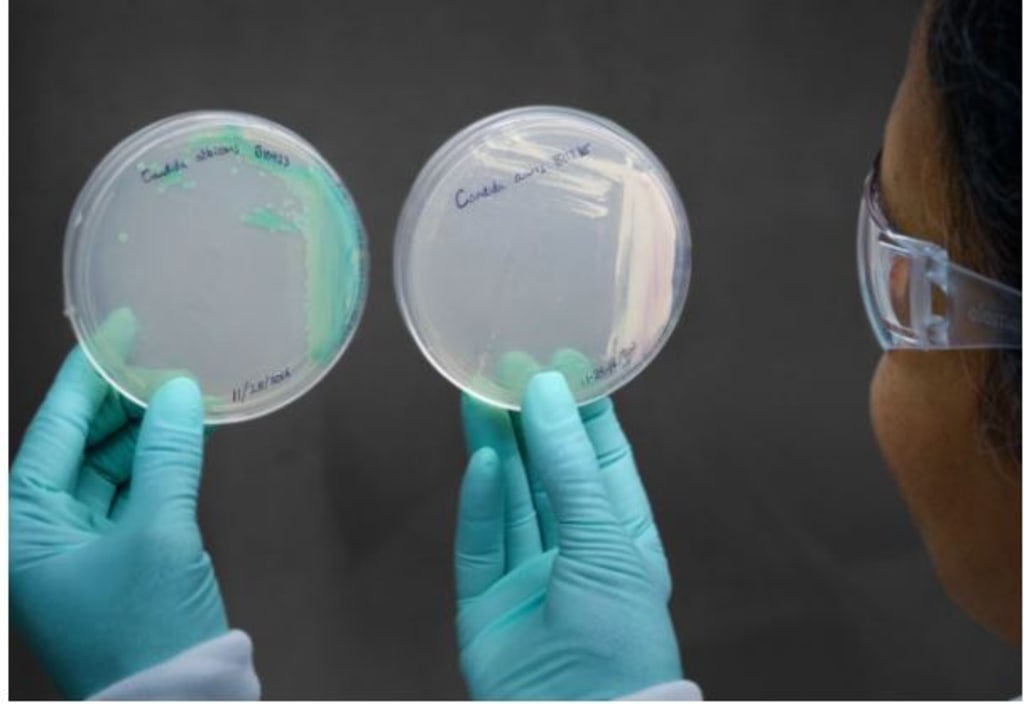

Superbug Hits 28 States, Including Alabama: Where the Deadly Fungus Is Spreading
Health officials warn that the drug-resistant fungus is spreading rapidly in healthcare facilities across the U.S.
Health officials across the United States are raising alarms as a dangerous fungal “superbug” continues to spread across the country. The organism, which has now been identified in at least 28 states including Alabama, poses a serious threat — particularly to hospitalized patients, older adults, and people with weakened immune systems.
While fungal infections rarely make headlines, this one has drawn national attention because of its high resistance to treatment and its ability to spread in healthcare settings. Public health experts warn that understanding where it is spreading — and who is most at risk — is critical to preventing further outbreaks.
What Is This Deadly Superbug?
The fungus at the center of concern is Candida auris, a type of yeast that can cause severe and sometimes fatal infections. Unlike more common fungal infections, Candida auris is particularly dangerous because it is often resistant to multiple antifungal medications, making it extremely difficult to treat.
First identified in 2009, the fungus has since emerged as a global health threat. In the U.S., cases were once rare, but over the past few years, infections have increased rapidly — prompting health agencies to classify it as an urgent antimicrobial resistance threat.
Why Candida auris Is So Dangerous
What makes Candida auris especially concerning is its ability to:
Resist standard antifungal drugs
Survive on surfaces for long periods
Spread easily in hospitals and nursing homes
Cause bloodstream infections with high mortality rates
Unlike many infections that spread person-to-person in the community, Candida auris primarily spreads in healthcare environments, where patients are already vulnerable.
Invasive infections can affect the blood, heart, brain, and other organs, leading to severe complications if not detected early.
Where the Fungus Is Spreading
Health authorities have confirmed cases in 28 states, including Alabama, with additional monitoring underway nationwide. While infections have been reported across multiple regions, clusters are most commonly linked to:
Hospitals
Long-term care facilities
Nursing homes
Rehabilitation centers
The fungus often spreads through contaminated surfaces, shared medical equipment, or prolonged patient contact, especially in facilities where infection control measures are strained.
Because Candida auris can live on bed rails, medical devices, and even clothing, outbreaks can be difficult to contain once the fungus is introduced into a facility.
Who Is Most at Risk?
Candida auris does not typically affect healthy individuals. The people most at risk include:
Older adults
Patients in intensive care units (ICUs)
Individuals with weakened immune systems
People with central lines, catheters, or ventilators
Long-term hospital or nursing home residents
For these groups, infection can quickly become life-threatening, especially when treatment options are limited due to drug resistance.
Symptoms Can Be Hard to Detect
One of the most challenging aspects of Candida auris is that symptoms are often nonspecific and can resemble other infections. Common signs may include:
Fever and chills that don’t improve with antibiotics
Low blood pressure
Fatigue
Organ dysfunction in severe cases
Because symptoms overlap with many other conditions, Candida auris is frequently misidentified, delaying appropriate treatment and increasing the risk of spread.
Why Cases Are Rising Now
Experts point to several factors contributing to the rise in cases:
Increased antimicrobial resistance
Overuse of antibiotics and antifungals has allowed resistant organisms to thrive.
Strained healthcare systems
Hospitals facing staffing shortages and overcrowding may struggle to maintain strict infection control.
More vulnerable populations
An aging population and higher numbers of immunocompromised patients increase risk.
Improved detection
Better testing has led to more cases being identified, though experts believe many still go undiagnosed.
How Health Officials Are Responding
Public health agencies are urging healthcare facilities to strengthen infection prevention protocols, including:
Enhanced cleaning with disinfectants effective against fungi
Strict hand hygiene
Isolation of infected or colonized patients
Screening high-risk individuals
Facilities are also being encouraged to report cases promptly to help track and contain outbreaks.
What the Public Should Know
While the spread of Candida auris is serious, the general public faces a low risk. Most infections occur in healthcare settings, not through casual contact in everyday life.
However, people with elderly family members or loved ones in long-term care facilities should:
Ask about infection control practices
Ensure facilities follow proper hygiene and cleaning standards
Advocate for early testing if symptoms arise
Awareness is one of the strongest tools in preventing further spread.
A Growing Public Health Challenge
The spread of Candida auris across 28 states, including Alabama, highlights a broader issue facing modern medicine: the rise of drug-resistant infections. As treatments become less effective, prevention and early detection become more critical than ever.
Health experts stress that addressing this threat will require coordinated efforts from hospitals, public health agencies, and policymakers — along with continued public awareness.
The fight against superbugs like Candida auris is far from over, and how the U.S. responds now may shape the future of infectious disease control for years to come.
About the Creator
Asad Ali
I'm Asad Ali, a passionate blogger with 3 years of experience creating engaging and informative content across various niches. I specialize in crafting SEO-friendly articles that drive traffic and deliver value to readers.



Comments
There are no comments for this story
Be the first to respond and start the conversation.